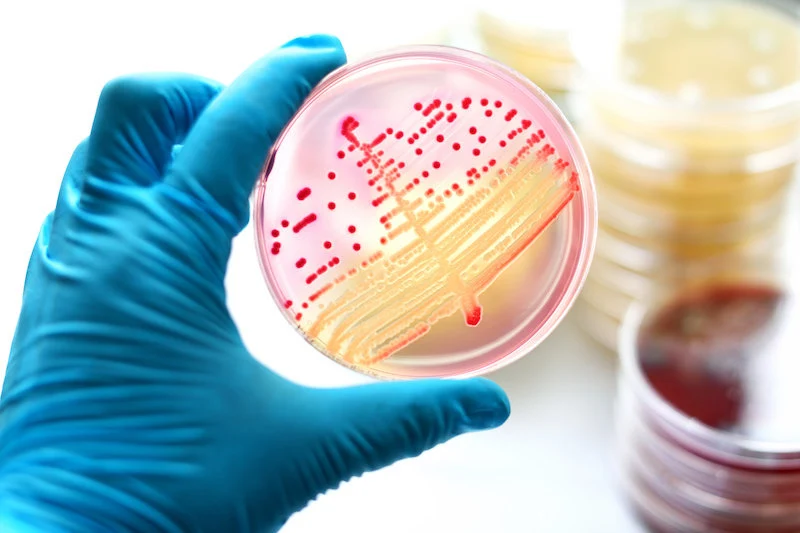

Biological cell-cell communication circuits / California Institute of Technology. Biologists often try to understand how life works by maki...
![]() |
| Biological cell-cell communication circuits / California Institute of Technology. |
Back in 2000, when Michael Elowitz of the California Institute of Technology was still a grad student at Princeton University, he accomplished a remarkable feat in the young field of synthetic biology: He became one of the first to design and demonstrate a kind of functioning “circuit” in living cells. He and his mentor, Stanislas Leibler, inserted a suite of genes into Escherichia coli bacteria that induced controlled swings in the cells’ production of a fluorescent protein, like an oscillator in electronic circuitry.
The molecular signaling systems of complex cells are nothing like simple electronic circuits, the logic governing their operation is riotously complex, but it has advantages.
It was a brilliant illustration of what the biologist and Nobel laureate François Jacob called the “logic of life”: a tightly controlled flow of information from genes to the traits that cells and other organisms exhibit. But this lucid vision of circuit-like logic, which worked so elegantly in bacteria, too often fails in more complex cells. “In bacteria, single proteins regulate things,” said Angela DePace, a systems biologist at Harvard Medical School. “But in more complex organisms, you get many proteins involved in a more analog fashion.”
Recently, by looking closely at the protein interactions within one key developmental pathway that shapes the embryos of humans and other complex animals, Elowitz and his co-workers have caught a glimpse of what the logic of complex life is really like. This pathway is a riot of molecular promiscuity that would make a libertine blush, where the component molecules can unite in many different combinations. It might seem futile to hope that this chaotic dance could convey any coherent signal to direct the fate of a cell. Yet this sort of helter-skelter coupling among biomolecules may be the norm, not some weird exception. In fact, it may be why multicellular life works at all.
“Biological cell-cell communication circuits, with their families of promiscuously interacting ligands and receptors, look like a mess and use an architecture that is the opposite of what we synthetic biologists might have designed,” Elowitz said. Yet this apparent chaos of interacting components is really a sophisticated signal-processing system that can extract information reliably and efficiently from complicated cocktails of signaling molecules. “Understanding cells’ natural combinatorial language could allow us to control [them] with much greater specificity than we have now,” he said.In this time-lapse video, bacteria in the channels of a microfluidics chip produce an orderly succession of fluorescent proteins under the control of a “repressilator,” an inserted genetic circuit. This kind of genetic control is much harder to establish in complex cells because their molecular signaling is more elaborate.
The emerging picture does more than reconfigure our view of what biomolecules in our cells are up to as they build an organism — what logic they follow to create complex life. It might also help us understand why living things are able to survive at all in the face of an unpredictable environment, and why that randomness permits evolution rather than frustrating it. And it could explain why molecular medicine is often so hard: why many candidate drugs don’t do what we hoped, and how we might make ones that do.
Messengers, Not the Messages
If you were designing a machine or an electronic circuit, it would be folly to model it after a cell. The components of cells are for the most part not carefully arranged and assembled, but are instead just floating and mixing inside the cell membrane like an unruly, jostling crowd. Yet somehow, it works.
The tidy, traditional explanation is that although the protein molecules that make up most of a cell’s working parts are constantly bumping into one another, they treat nearly all of these encounters with indifference. Only when a protein meets another molecule that meshes exactly with an exquisitely sculpted part of its surface do the two lock together and interact. These processes of precise molecular recognition maintain clear lines of communication within cells and keep them running. The only problem with this story is that it is wrong. Although many proteins do exhibit selective molecular recognition, some of the ones most central to the workings of our eukaryotic cells are far less picky.
![]() |
| Michael Elowitz, a systems biologist at the California Institute of Technology / Jeff Lewis. |
But although it is indeed involved in that — malfunctions in BMP production are implicated in bone-growth diseases — the idea that bone growth is the function of BMP proteins has long since proved illusory. One type of BMP is involved in the developmental process called gastrulation, which happens around 14 days after fertilization in human embryos, when cells start to specialize into different tissue types and the embryo changes from a clump of cells into a far more complex structure. Later, BMPs are also expressed in cartilage, the kidneys, the eyes and the early brain, and they guide the development of those tissues.
The reality is that the function of BMPs cannot be defined by their effects on the phenotype (that is, on traits). They mediate communications between cells, but what that communication triggers can be totally different in different types of cells, or in the same cell type at a different stage of development. BMPs are messengers, not messages.
What Elowitz and others are now bringing to light is how BMPs pull off this trick of being so mercurial while also behaving predictably enough for organisms to stake their lives on them. These qualities seem to emerge from the layers upon layers of complexity in the composition of the BMP system, and the flexible, variable affinities of those elements for one another. Paradoxically, the complexity makes the system both more precise and more reliable.
Mammals have genes that encode 11 or more distinct BMP proteins, each with a slightly different structure. BMPs act in bound pairs, or dimers, of the same or different proteins, and in some cases these dimers pair up too, further multiplying the variations. The family of BMP proteins sticks to an associated family of receptor proteins — and those receptors are also made from subunits that fit together in small groups, typically four at a time. It’s this whole cluster of molecules that activates the transcription factors turning genes on and off and triggering a downstream effect on the host cell.
It’s not simply the case, however, that each BMP dimer has designated receptors to which it binds like a lock and key. In fact, these molecules aren’t terribly choosy: Each BMP dimer may stick to several different pairs of receptor subunits with varying degrees of avidity. It’s a combinatorial system, in which the components can be assembled in many ways: less like locks and keys, more like Lego bricks.The possible permutations are exhausting to contemplate. How can the BMP pathway ever deliver a specific directive to guide a cell’s fate? With so much complexity, “it took a little unconventional thought to approach the problem,” said James Linton, a research scientist in Elowitz’s group.
The Caltech team, along with Yaron Antebi, a former postdoc with Elowitz who is now at the Weizmann Institute of Science in Israel, undertook experimental and computational studies to characterize the binding propensities between 10 major mammalian forms of BMPs and seven receptor subunits in two types of mouse cells. That involved studying a lot of combinations, but an automated robotic system for carrying out the reactions in cell cultures made it possible.
The interactions, although promiscuous, were far from “anything goes.” Certain BMPs had nearly interchangeable effects, but others did not. In some cases, one BMP plus two receptor subunits worked as well as an assembly of three different components. An assembly might work as well with one BMP swapped for another, but only if the receptor stayed the same. Sometimes two swapped components had independent effects, and their combined effect was a simple sum. Sometimes the effects mutually reinforced one another or canceled each other out.
![]() |
| Olena Shmahalo / Quanta Magazine. |
More Specificity From Fewer Signals
Why does BMP signaling work in a way that seems so unnecessarily complicated? The Caltech team speculates that it might give organisms more for less. Mathematical modeling by members of the group — Christina Su at Caltech, Antebi in Israel and Arvind Murugan at the University of Chicago — showed that a promiscuous system of interactions offers a range of potential advantages over one-to-one molecular interactions.
In particular, in systems where ligands bind uniquely to receptors, the number of types of ligands limits how many different cell types or targets can be uniquely addressed. In a combinatorial system, different pairings between a small number of ligands and receptors can specify a much larger number of targets. The differences between the pairings also permit graded effects rather than an all-or-nothing response.
![]() |
| Yaron Antebi, a biologist now at the Weizmann Institute of Science / Quantum Magazine. |
The many possible combinations might create some fuzziness at boundaries between regions, but Linton speculates that these might be sharpened by operating in conjunction with other signaling systems. A pathway involving the family of proteins called Wnt, for example, often seems to operate alongside BMP signaling. “If you find BMP at work somewhere, it’s very likely that you’ll find Wnt,” Linton said. Sometimes the pathways are mutually antagonistic and sometimes they enhance each other. If the Wnt pathway follows similar combinatorial rules — a possibility that still needs to be explored experimentally, Elowitz stresses — then BMP and Wnt might help to refine each other’s signaling.
Elowitz and his colleagues think that in this way, these kinds of combinatorial rules could represent a widespread “design principle” of the molecular wiring of cells. It’s a combinatorial system, in which the components can be assembled in many ways: less like locks and keys, more like Lego bricks. The systems biologist Galit Lahav of Harvard Medical School agrees that such a system makes a lot of sense. She wonders if something similar might apply to the gene p53, which is central to controlling cells’ cycles of replication and division and is often implicated in cancers. The p53 protein plays several different roles in cell signaling, and it binds to many other molecules.
The combinatorial principle might also extend to situations beyond cell growth and development. Linton sees a loose parallel with what seems to happen in the olfactory system: Humans have around 400 types of receptor proteins lining the membranes of the olfactory bulb in the nose, and these receptors can collectively discriminate vast numbers of odors. That wouldn’t be possible if each odorant molecule had to be uniquely recognized by its own dedicated receptor. Instead, the receptors seem to bind promiscuously to odorants with different affinities, and the output signal sent to the brain’s smell center is then determined by combinatorial rules.
Using Noise to Their Advantage
The evidence that interactions of proteins, RNA molecules and DNA genomic sequences involved in cell regulation are flexible and promiscuous has become ever more prevalent in the past decade or so. They turn up in a wide range of systems throughout biology. “Given that promiscuity did not have to exist, but is ubiquitous, the simplest and most reasonable assumption is that it is providing some functional capability,” Elowitz said.
He thinks that capability is, at root, information processing. “Just as neurons wired together through axons and dendrites can perform complex information processing, so too can proteins wired together through biochemical interactions,” he said. It’s an insight that other scientists have also drawn from their studies of biochemical networks.
Heidi Klumpe, a member of Elowitz’s group who conducted much of the experimental work on the BMP system, compares it to the way neural networks work: not by assigning fixed roles to given components of the network, but by letting the roles emerge from many connections. “We think the cells are doing a more complex computation than previously thought,” she said.
Our working hypothesis is that these ligand-receptor combinations have the potential to be more cell-type-specific than individual molecules. “What we are trying to do now is figure out precisely what kinds of functions these systems actually compute,” Elowitz said, “and what higher-level capabilities these computations then enable.”
The evolutionary biologist Andreas Wagner of the University of Zurich agrees that the idea that a promiscuous system like this has been selected because it confers some advantage is “right on the mark.” That this benefit may lie in its versatility is “an intriguing possibility that has probably crossed the mind of anybody who seriously thought about this problem,” he said.
But he adds that “there is another, more mundane possibility”: Perhaps this is the only way a complicated system like the cells of multicellular organisms can work at all. “Cellular systems are highly noisy,” Wagner said; molecular encounters in the crowded, jostling environment inside cells are unpredictable, and the amounts of proteins produced from moment to moment fluctuate randomly. A cell in which each component is wired specifically to another would be highly vulnerable to those uncontrollable variations. It would behave as though circuit elements kept dropping randomly in and out of the network.
Moreover, every time a cell divides, there’s no guarantee that circuits will get exactly reproduced because of random copying errors in DNA replication. “A system like that might be exquisitely sensitive to mutations that alter its properties,” Wagner said. “Taken together, all these costs might well be prohibitive.” Consequently, cells may have evolved adaptations that use noise to their advantage, and Elowitz’s model of the combinatorial logic of regulatory networks “may be one example of such adaptation,” Wagner said. “Cells may have sloppy systems whose power emerges from the right kind of combinatorics.”
“Biological systems are generally much more robust than we imagine,” said Meng Zhu, a developmental biologist at Harvard Medical School. Researchers often find that when they experimentally disable a gene that appears critical to survival, the organism barely seems to notice: It readjusts the interactions and pathways in its gene and protein networks to compensate. The redundancy and the compensatory function of related proteins, as seen in the BMP system, might be a key part of that ability, she says.
Zhu thinks that promiscuous, highly interconnected protein networks might also promote the ability of organisms to acquire useful new capacities through evolution. “A system that has higher connectivity tends to evolve new functions more easily,” she said, because it can better tolerate deleterious mutations in its component parts.
Conversely, if all the interactions between the molecular components are very finely tuned, “it’s very hard to do something new,” said Ard Louis, a physicist who works on problems of biological complexity at the University of Oxford. Any change in those components, even one that seems advantageous, is likely to disrupt some existing, possibly vital function.
Promiscuous binding that allows one protein to substitute for another might therefore enable the network to acquire new functions without losing the old ones. Wagner, working with Joshua Payne at the Swiss Federal Institute of Technology Zurich, has found support for this idea: They have shown that the promiscuous binding of transcription factors can promote both robustness to mutations and the ability to evolve new functions.
So it could be that a combinatorial system of ligand binding both creates more options for cells and gives organisms more evolvability and robustness against noise. Evolution may have organized much of the cell’s biochemistry to be far less sensitive to the details than researchers thought. “I think noisy, evolved biological systems are full of details, but a lot of them are irrelevant,” Klumpe said. “Moreover, it may not be a specific detail that matters, but rather the conservation of some higher-level function” — such as the requirement that transcription factors bind with some level of strength to turn on gene expression.
Circuitry Is Too Simple
This kind of “sloppiness” in biomolecular networks may have important consequences for drug development. “One of the challenges in ordinary medicine is that drugs can be very specific for a target protein, but that target protein may be nonspecific in terms of the cell types in which it is expressed,” Elowitz said. You might be able to hit a protein target very accurately but still not know what effect that will have in different tissues — if any. The work of Elowitz’s team suggests that drugs may need to be more than single-molecule “magic bullets”: They might have to hit different combinations of tissue-specific targets to induce the desired response.
Whatever the reason for its combinatorial principles, the BMP signaling system shows that cells are not like the machines we humans make. “And it might be that that’s true for many biological systems,” Linton said. “If you make simple analogies to electronics, you’re going to come up short.”
This makes it challenging not just to talk about biological systems but to understand and engineer them. Electronic analogies might be appropriate for relatively simple systems such as the bacteria that Elowitz and Leibler worked on 20 years ago, but when living organisms get more complicated — and in particular when they become multicellular, with genetically identical cells that work together in diverse, specialized states — different rules may apply.
The operating principle exemplified by the BMP system might be “something that emerged in nature as a way to give rise to multicellularity and more complex tissues,” Linton said. It’s even possible, he suggests, that “this was the innovation that allowed organisms such as us to emerge.” Perhaps, then, the most useful analogies for how cells work are themselves biological, such as olfaction or cognition. Maybe the only way to truly understand life is with reference to itself.